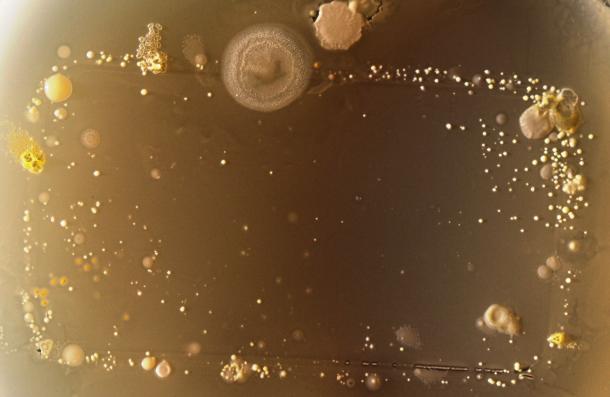
Foto Mikroskop Bakteri yang Bersemayam pada Ponsel 11

smartphone
Embrace+, Gelang Pintar yang Dapat Terhubung Pada Smartphone
Detail Penerus Flagship Sony Xperia Z Terkuak?
Acer Siap Masuk ke Persaingan Phablet?
LG Resmi Meluncurkan LG Optimus G!
Fujitsu Hadirkan Smartphone Khusus untuk Para Lanjut Usia
Samsung Forum 2013: Pagelaran Produk Terbaru
Sony Siap Rilis Smartphone Berbasis Firefox OS Tahun Depan?
Blackberry Z10 Lebih Laku Dibanding iPhone
Samsung Resmi Hentikan Pengembangan Bada OS
Spesifikasi Smartphone ZTE Berbasis Firefox OS Muncul ke Permukaan
Foto Mikroskop Bakteri yang Bersemayam pada Ponsel
VOYAGER, Smartphone Didesain Khusus untuk Mobil
Nvidia Tegra 4 Siap Diusung oleh ZTE Untuk Smartphone Generasi Berikutnya
Nokia Tidak Lagi Gunakan Komponen dari Samsung
Setelah Smartphone, Ubuntu Juga Siap Bersaing di Pasar Tablet
Gadget
Review Infinix GT 30: Smartphone Gaming Padahal Aslinya All-Rounder!
Ini adalah Infinix GT 30! Ya, hape ini adalah versi lebih terjangkau dari Infinix GT 30 Pro yang sudah pernah kita review. SoC nya pakai Dimensity 7400. Main Mobile Legend bisa sampai 120 fps! Suhunya juga nggak gampang panas. Fitur bypass charging juga ada. Layarnya AMOLED dengan bezel tipis. Yang nggak kalah penting, dia juga […]
Fossil Hadirkan Dua Jam Tangan Kolaborasi Marvel Fantastic Four
Fossil mengumumkan hadrinya dua jam tangan eksklusif hasil kolaborasi Marvel Studios Fantastic Four: First Steps. Jam tangan pertama mengusung desain mirip jam tangan komputer milik Mr Fantastic. Sedangkan jam tangan kedua punya desain yang terinspirasi Galactus, sang villain. Jam kolaborasi yang pertama adalah LE1210SET. Desainnya terinspirasi dari jam tangan komputer milik Reed Richard, sang Mr […]
Review “Singkat” Samsung Galaxy S25 Edge: Smartphone Pemicu Pro-Kontra! Sebaik/Seburuk Itu?
Ini hape yang memicu Pro-kontra. Banyak orang, bahkan kami pun tidak yakin dengan hape ini saat pertama kali spesifikasinya diumumkan. Asumsi awalnya: ini hape yang speknya dipangkas, boros, performa rendah, dan kemahalan. Cuma modal penampilan saja. Ini membuat terjadinya pro kontra, antara yang sudah beneran pakai versus yang hanya bahas spek atau hanya pegang-pegang sebentar […]
Review Amazfit Active 2 Square: Smartwatch “Kotak” yang Klasik, Canggih, dan Baterai Awet!
Kalian sedang cari smartwatch bentuk kotak yang canggih, baterai irit, fitur melimpah tapi ukurannya gak terlalu besar? Yang satu ini mungkin bisa jadi jawabannya. Ini adalah Amazfit Active 2 Square Premium Edition. Desainnya kotak dengan gaya klasik, tapi ukurannya tetap ringkas dan ringan! Layarnya AMOLED dengan tampilan yang keren, dan pakai Sapphire Glass, jadi lebih […]
Laptop
Review ADVAN Workmate Ultra: Laptop Intel Core Ultra di Bawah Rp 8 Juta?!
Laptop pakai Intel Core Ultra 5 cuma Rp 8 Juta? ADVAN beneran, nih? Iya, yang satu ini sudah pakai Intel Core Ultra 5 115U. Biasanya, laptop harga segini tuh prosesornya masih pakai Intel Core Generasi ke-12 loh, keren nih! Dan karena namanya Core Ultra, prosesornya juga udah dilengkapi NPU nih. RAM-nya 8 GB dan masih […]
Review Lenovo Legion Pro 5 Gen 10: Laptop 16-Core Buat Kerja Berat & Main Game AAA
Hei Lenovo! Kalian itu mau sedekah?! Masa’ harga Laptop Gaming ini masih sama kayak tahun lalu? Padahal harga RAM dan SSD lagi mahal banget. Kapasitas RAM Laptop ini bukan 16 GB lho, tapi 32 GB DDR5. Tahu kan berapa harga RAM Laptop 32 GB DDR5?! Bahkan SSD-nya juga langsung 1 TB, bukan 512 GB. Prosesornya […]
Review Acer Swift X 14 AI 2026: Tipis, Ringan, Kenceng Buat Gaming, Editing Video dan Desain 3D!
Laptop mewah yang satu ini, bukan hanya tipis dan ringan, tapi juga kuat dipakai buat kerjaan berat! Mau desain 2D? Edit foto? Video? Atau bahkan sampai desain 3D juga kuat! Karena yang satu ini prosesornya pakai Intel® Core™ Ultra 9 285H. Dan ini punya diskrit GPU yang kenceng loh, pakai NVIDIA GeForce RTX 5060 Laptop! […]
Review ASUS Zenbook 14 OLED (UM3406GA): Laptop Tipis-Ringan Kelas Atas dengan AMD Ryzen AI 400
Ini dia Laptop tipis dan ringan terbaru dengan prosesor “AMD Ryzen AI 400 Series”. Performa pastinya kekinian karena CPU-nya udah Zen 5 dan GPU-nya RDNA3.5. Pake RAM 16 GB LPDDR5X juga jadi langsung kencang performanya. Layarnya OLED 100% DCI-P3 jadi cocok buat Editing yang serius. Baterainya juga irit, lebih dari 19 jam, jadi bisa buat […]
Gaming
Co-Founder Embark Studios Tinggalkan Perusahaan Akibat Tuduhan Pelecehan
Co-founder Embark Studios, Rob Runesson, keluar dari studio itu setelah tuduhan pelecehan, meski investigasi tidak menemukan bukti kuat.
Kabar suram datang dari kreator ARC Raiders dan The Finals, Embark Studios, dengan kabar co-founder sekaligus Chief…
Death Stranding 2 Perlihatkan Konten & Fitur Baru Jelang Rilis di PC
Mendekati rilisnya di PC, Death Stranding 2 perlihatkan adanya konten dan fitur baru yang akan diberikan di sana.
Ternyata beragam peningkatan teknis yang akan hadir di Death Stranding 2: On the Beach versi PC hanyalah satu bagian saja dari beragam hal…
Pimpinan Take Two Sebut AI Tak Bisa Ciptakan Game Yang Sukses
Pimpinan Take Two, Strauss Zelnick, menegaskan bahwa AI hanya dapat membantu pembuatan aset belaka, bukan menjamin kesuksesan game.
Masih ingatkah Anda dengan Project Genie buatan Google, yang sempat guncang industri gaming hingga sebabkan harga saham …
Kreator MindsEye Berpisah Dari Publisher IO Interactive
Publisher IO Interactive resmi mengakhiri kerja samanya dengan Build a Rocket Boy untuk terbitkan MindsEye, sekaligus membatalkan crossover Hitman.
Kabar buruk kembali menimpa kreator dari MindsEye, studio Build a Rocket Boy (BARB). Setelah sebelumnya …
Direct Release
- Blibli XPO THR Fest 2026: Promo Triple Zero 0% dan Perlindungan Lengkap hingga 36 Bulan Hadir di MARGOCITY!
- Laporan Group-IB Ungkap Serangan Siber pada Rantai Pasok Akan Mengubah Lanskap Keamanan Siber Asia-Pasifik di 2026
- ZTE dan MyRepublic Indonesia Luncurkan Proyek Ascend
- Dreame Gelar Opening Store di AEON Deltamas Bekasi Tawarkan Banyak Promo Menarik
- Signature Upgrade: Kolaborasi erafone dan XL PRIORITAS Hadirkan Cara Baru Miliki iPhone Terbaru Setiap Tahun
Techno Update
- Jangan Asal Beli Lampu! Ini Tips Pencahayaan Konten yang Perlu Dipahami
- Kasus Crowdstrike Bikin Rugi, Synology Bagikan 5 Tips Perkuat Ketahanan Sistem IT
- Tips Memilih Printer Multifungsi Untuk Kebutuhan Rumah (Feat. Brother)
- 20+ Kursus/Pelatihan GRATIS Bidang IT Bersama Trainer Profesional
- Tips Memilih Laptop Untuk Pelajar, Kuliah dan Pekerjaan Ringan
Gadget
Laptop
Gaming
Components
Accessories
Components
- Upgrade NVIDIA RTX 2060 Super / RTX 3060 Ti ke RTX 5060 Ti 16 GB: Worth It?
- 96 Core Jalan Di 5.8 GHz, Ryzen Threadripper PRO Pecahkan Rekor Baru!
- Review Colorful iGame GeForce RTX 5080 Advanced OC: Garang, Kencang untuk 4K, Dingin, dan Kaya Fitur
- Review NVIDIA GeForce RTX 5090 FE: Kencang, Banyak Fitur Baru, Bodi Tipis, Suhu Tetap Aman
Accessories
Direct Release
- Blibli XPO THR Fest 2026: Promo Triple Zero 0% dan Perlindungan Lengkap hingga 36 Bulan Hadir di MARGOCITY!
- Laporan Group-IB Ungkap Serangan Siber pada Rantai Pasok Akan Mengubah Lanskap Keamanan Siber Asia-Pasifik di 2026
- ZTE dan MyRepublic Indonesia Luncurkan Proyek Ascend
- Dreame Gelar Opening Store di AEON Deltamas Bekasi Tawarkan Banyak Promo Menarik
- Signature Upgrade: Kolaborasi erafone dan XL PRIORITAS Hadirkan Cara Baru Miliki iPhone Terbaru Setiap Tahun
Techno Update
- Copilot 3D Ubah Gambar 2D Jadi 3D Cuma 1 Klik, Gratis! Ini Cara Menggunakannya!
- Jangan Asal Beli Lampu! Ini Tips Pencahayaan Konten yang Perlu Dipahami
- Kasus Crowdstrike Bikin Rugi, Synology Bagikan 5 Tips Perkuat Ketahanan Sistem IT
- Tips Memilih Printer Multifungsi Untuk Kebutuhan Rumah (Feat. Brother)
- 20+ Kursus/Pelatihan GRATIS Bidang IT Bersama Trainer Profesional